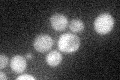
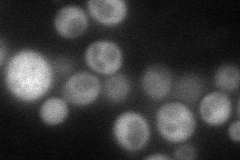
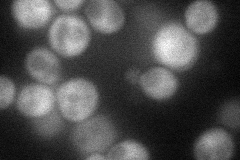
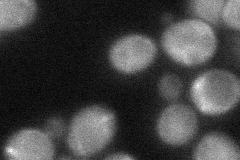
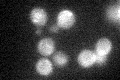
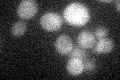

View description
Carbon source-responsive zinc-finger transcription factor, required for transcription of the glucose-repressed gene ADH2, of peroxisomal protein genes, and of genes required for ethanol, glycerol, and fatty acid utilization
Localization:
Intensity:
Fold change:
Significance:
-
C’ GFP library in SD
cytosol22.11 -
N' NOP1pr-GFP in SD
cytosol59.7755 -
N' TEF2pr-mCherry in SD
cytosol48.5382 -
N' NATIVEpr-GFP in SD

cytosol30.7681 -
N' TEF2pr-VC and Cyto-VN in SD
cytosol41.9283 -
C’ GFP library in SD+DTT

cytosol36.461.64Yes -
C’ GFP library in SD+H2O2
cytosol24.931.12No -
C’ GFP library in Starvation Media
cytosol20.660.93No -
C’ GFP library on the background of Pup2-DaMP

cytosol -
C’ GFP library on the background of CCT mutant

cytosol24.28941.09803No
